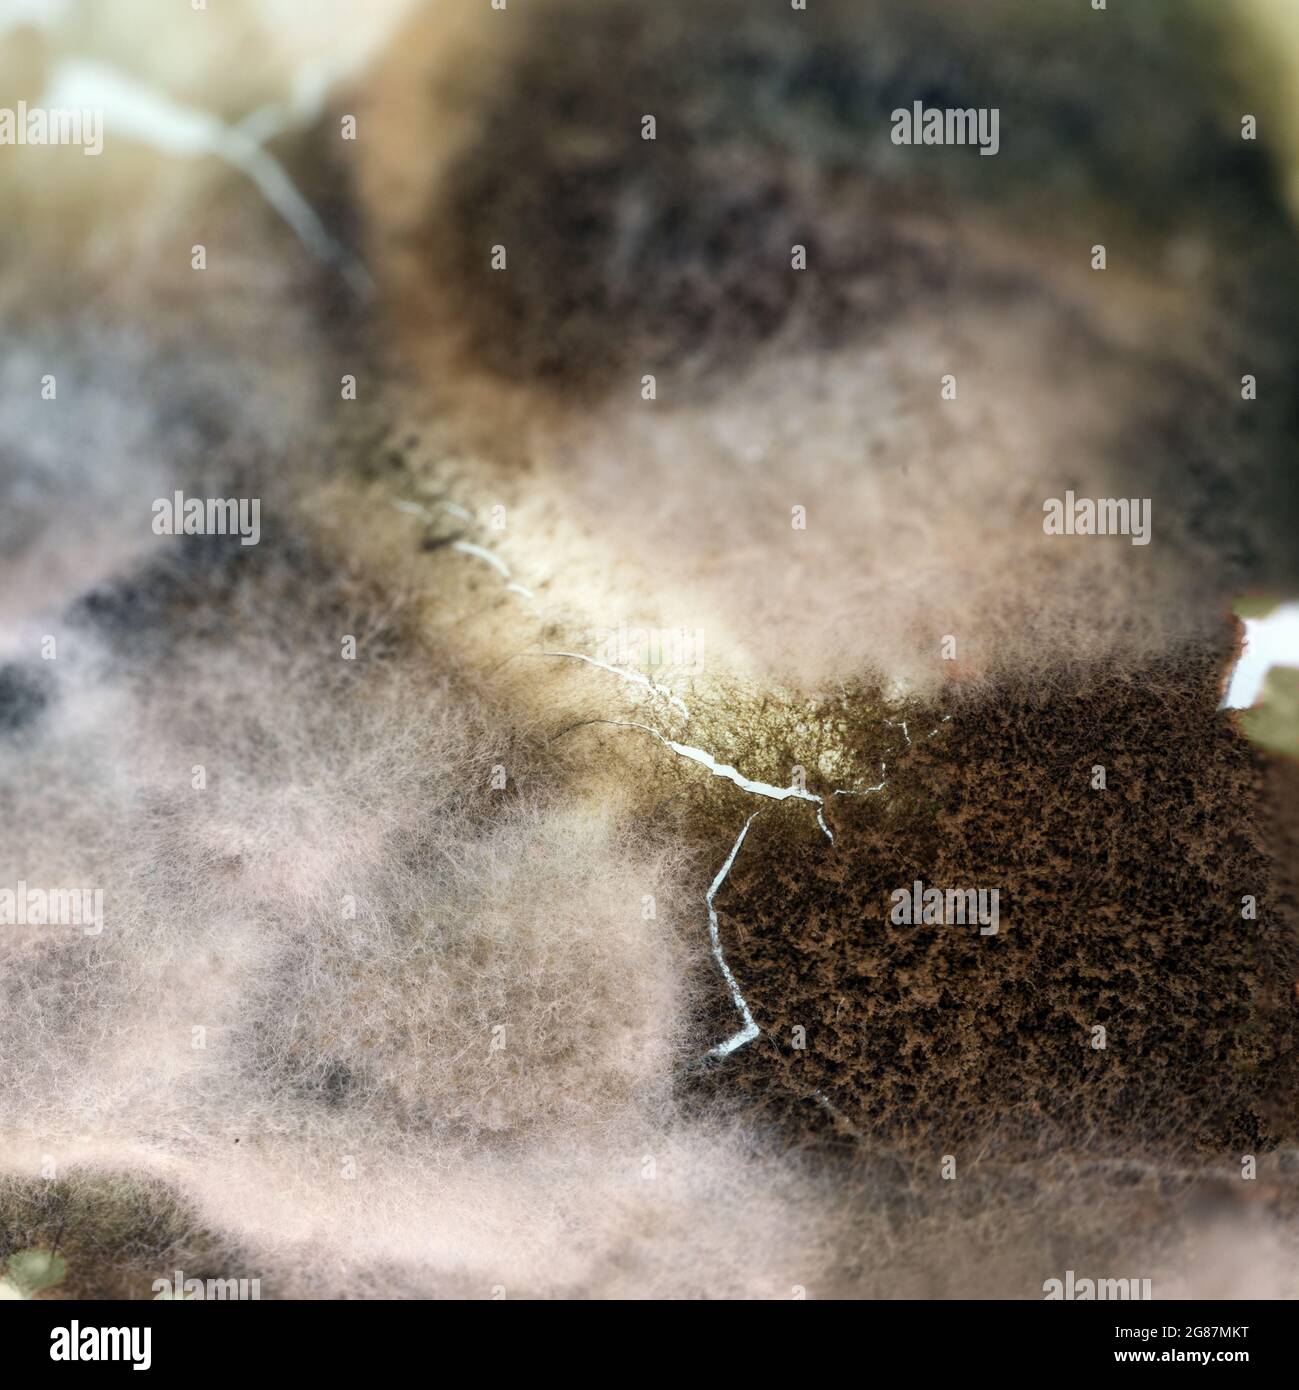
Muffa funghi che crescono sul coperchio di un prodotto lattiero-caseario, cibo rovinato dopo il meglio prima della data, astratta trama di fondo per la salute e igiene con Foto Stock

Concetto viziato Immagini Stock
(4,048)Filtri rapidi:
Concetto viziato Immagini Stock

RM2C2MR2F–Mele marcio e bianche su un mucchio di composto in giardino. Concetto di prodotti viziati. Pila di mela marcio

RFGETTKH–Marcio simbolo alimentare e viziati orribile concetto di pasto come una forcella tenendo un imbarazzo apple con funghi che crescono con 3D illustrazione elementi come una metafora per i pasti che non sono fresche.

RM2J2WYWD–Una bottiglia di plastica per bevande, una bomboletta di alluminio e altri rifiuti catturati in un'area di mare sulle rive della baia di Chittaway nel nuovo Galles del Sud, Australia

RFM4GJNH–I giovani ben fleshed uomo in papillon e occhiali avente espressione facciale di disapprovazione e disgusto.

RF2CFRXT0–Frutta rovinata nel sacchetto di plastica su sfondo grigio. Spazzatura discarica cibo marcio. Concetto di zero sprechi. Immagine con spazio di copia, orizzontale.

RMC87JH3–Bandiera dell'UE a brandelli, concept, strappata, ragged, rovinato, in rovine, rotto, rotte, sconsolato, coccolati e viziati, Europa, Europea, CEE,

RF2RFNG0X–Una crisalis morta e viziata di una farfalla Tailed Green Jay è appesa sotto una foglia, vedendo attraverso le foglie

RF2G87N58–Tappeto di funghi di stampo bianco e nero che copre crema viziata, concetto di cibo, struttura astratta di sfondo per la salute e l'igiene, copy space, macro

RF2D9PFTJ–Formaggio rovinato in confezione su sfondo blu. Concetto di spreco di cibo. Orientamento verticale. Spazio di copia.

RF3C3W16B–Mele fresche e viziate in una cassa di legno - tradizionale raccolto e stoccaggio, concetto di agricoltura locale

RFF5DH4F–Cibo contaminato concetto e inquinato pasto simbolo di avvelenamento risultante in malattia dovuta a pericolosi batteri tossici parassiti e viruse contaminanti come la salmonella e e coli come aperto.

RM2A6PJ20–Un mezzo sepolto barca motore giace arrugginimento e corrosione nella sabbia tra le rocce su una spiaggia vicino Bundeena nel sud di Sydney, Australia

RF2AB2M59–I rifiuti alimentari problema concetto. Guastato cibo nel cassonetto. Il marcio arance e mele vicino. I problemi ecologici.

RF3CW2EGF–primo piano di grani di pepe misti ammuffiti, bacche nere, verdi e marroni rovinate con crescita fungina, concetto di spreco di spezie e risultato di cibo improprio

RF2M4XR8B–Una farfalla morta di colore blu e macchie nere sulle ali sta avendo un po 'rovinato e danneggiato caduta del corpo sul terreno sabbioso

RF3CTBA8Y–Primo piano di una patata malata e marcificante isolata su sfondo bianco. Concetto di spreco alimentare, contaminazione, malessere agricolo, verdure viziate

RF2AT8N4B–tre limes viziati si trovano in un sacchetto di plastica sul tavolo. Il concetto di frutta e agrumi in plastica. Vita senza sprechi e senza plastica. Salvare il

RF2D9PFY1–Diversi pezzi di formaggio guastato con funghi su sfondo blu. Concetto di spreco di cibo. Orientamento orizzontale. Spazio di copia.

RF3D5A5TF–Muffa multicolore su pane raffermo di segale. Spore fungine, muffa sul pane, macro. Primo piano di funghi colorati e ammuffiti sul cibo. Concetto di cibo viziato.

RF2GD9NKW–Fondere caldo e sgocciolare pianeta inabitabile Terra, riscaldamento globale cambiamento climatico concetto

RFKWNN6W–Arancio ammuffiti rimosso dal cerchio di quelli buoni. Concetto per i cattivi fuori di quelli buoni.

RF2E0T16B–Vista piatta del contenitore della tavolozza dell'ombra dell'occhio vuota rotto con molti colori. Concetto astratto di sfondo.

RFEPKCM3–L intossicazione alimentare concetto e foodborne malattia come cappello da cuoco con una bocca aperta con vomito sporgente verso l'esterno come un simbolo per la contaminazione e inquinato pasto causate da batteri come Salmonella o la gastroenterite contaminazione.

RM2A6PJWW–Sulla altrimenti incontaminata spiaggia di Sydney un parzialmente degradato Styrofoam McDonalds cup giace lavato fino sulla sabbia a Bundeena, Australia

RF2K8WB7C–Avanzi gettati nel composto. Cibo e raschietti rovinati. Ravvicinato di mele e pere. Questioni ecologiche. Spazzatura. Concetto di spreco di cibo

RF2G87MYA–Deterioramento del cibo con funghi di muffa e batteri di serratia in una confezione di formaggio cagliato, salute e igiene concetto, copia spazio, macro shot

RF2D9PFTR–Formaggio rovinato in confezione su sfondo blu. Concetto di spreco di cibo. Vista dall'alto. Orientamento orizzontale. Spazio di copia.

RF3D5A612–Spore fungine, muffa sul pane, macro. Muffa multicolore su pane raffermo di segale. Primo piano di funghi colorati e ammuffiti sul cibo. Concetto di cibo viziato.

RF2GD9NME–Fondere caldo e sgocciolare pianeta inabitabile Terra, riscaldamento globale cambiamento climatico concetto

RFTAB6AG–Alimentare il problema dei rifiuti e avanzi di cibo buttato nella spazzatura. Guastato cibo nel cassonetto. I problemi ecologici. Concetto di cibo la riduzione dei rifiuti.

RF3BH4YFH–Simbolo del dollaro con crepe sul muro. Concetto di crisi finanziaria. Spazio per il testo

RF2PYCG6R–Didascalia concettuale Stop Ego. Concetto del Internet controlli la vostra ossessione circa una decisione o un evento o qualche cosa

RM2M7MWCK–Mela rovinata, disidratata e marcio, una mela tagliata a metà, due metà di mela, isolata su fondo bianco

RFF7RWYG–Nero smartphone con il vetro rotto e stetoscopio. Concetto di necessità di cura per la riparazione. In astratto rotto, non si può tornare indietro.
RF2G87MKT–Muffa funghi che crescono sul coperchio di un prodotto lattiero-caseario, cibo rovinato dopo il meglio prima della data, astratta trama di fondo per la salute e igiene con

RM3CNRNE7–Bottiglia di condimento per insalata viziata in un lavandino della cucina quando le istruzioni per tenere in frigorifero vengono ignorate, 2025, Stati Uniti

RF2D9PG0F–Diversi pezzi di formaggio guastato su sfondo grigio. Concetto di spreco di cibo. Orientamento verticale. Vista dall'alto. Spazio di copia.

RF3D5A61A–Spore fungine, muffa sul pane, macro. Muffa multicolore su pane raffermo di segale. Primo piano di funghi colorati e ammuffiti sul cibo. Concetto di cibo viziato.

RF2CFRXRM–Cibo viziato. Kiwi, banana, arancio e avocado nel sacchetto di plastica. Rifiuti alimentari. Spazzatura discarica cibo marcio. Spazio di copia. Concetto di frutta marcio.

RF2G8YBBW–Mezza mela marcio. Mela rossa con sezione rovinata marrone decomposta, morbida e squishy. Concetto per rifiuti alimentari e sicurezza alimentare o mela malata. Isolato su

RMC2K0C6–Piccola casetta per uccelli utilizzati come decorazione. Piccoli uccelli case stringhe allegate appeso. Decorazioni da giardino a Keukenhof Olanda.

RF2RFH65D–la zucca è viziata e ricoperta da una grande quantità di muffa e tracce di marciume, viziata e pericolosa per la salute marcisce la zucca arancione

RF3BFDYWY–Rifiuti organici di cucina domestica pronti per compostare. Concetto ecologico. Avanzi di cibo, Peelings di verdure sul tavolo da cucina. Rispetto dell'ambiente

RF2PYET7M–Visualizzazione concettuale Stop Ego. Concetto di business Controlla la tua ossessione su una decisione o un evento o qualsiasi altro

RM2M7MWCW–Mele rovinate, disidratate e marciume, una mela tagliata a metà, due metà di mele, frutta isolata su fondo bianco

RFF7RWFE–Nero smartphone con il vetro rotto e stetoscopio. Concetto di necessità di cura per la riparazione. In astratto rotto, non si può tornare indietro.

RF2WE4K3W–Le cipolle germogliano durante la conservazione. Conservazione di prodotti, giardinaggio e cibo viziato.

RF2D9PG1A–Diversi pezzi di formaggio guastato su un piatto bianco su sfondo grigio. Concetto di spreco di cibo. Orientamento verticale. Spazio di copia.

RF2AYM2EA–Due ragazze amici studenti cercando salsiccia con impasse di disgusto sul loro volto. Il concetto di fast food viziato

RF2SWGH6Y–Cipolla troppo cotta in una padella. Una pessima cucina. Il concetto di alimenti nocivi e cancerogeni.

















































